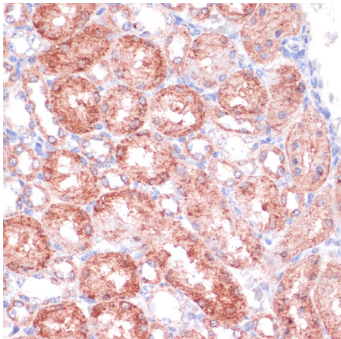
SHMT1 Antibody

154 results for "SHMT1 Primary Antibodies" in Products
SHMT1: Antibodies
R&D Systems offers high quality SHMT1 antibodies from Novus Biologicals brand. Our SHMT1 antibodies have been validated in multiple research applications, including Immunohistochemistry, Western Blot, ELISA, Immunocytochemistry/ Immunofluorescence, and Immunoprecipitation. These antibodies are reactive in Human, Mouse, and Rat. Our catalog includes anti-SHMT1 monoclonal, and polyclonal antibodies.
Choose the anti-SHMT1 antibodies best suited for your needs by reviewing citations, validation ...
| Reactivity: | Human |
| Details: | Rabbit IgG Polyclonal |
| Applications: | IHC, WB, ICC/IF |
| Reactivity: | Human, Mouse |
| Details: | Rabbit IgG Polyclonal |
| Applications: | IHC, WB, ELISA, IP |
| Reactivity: | Human, Mouse, Rat |
| Details: | Rabbit IgG Polyclonal |
| Applications: | IHC, WB, ELISA, ICC/IF |
| Reactivity: | Human |
| Details: | Mouse IgG1 kappa Monoclonal Clone #AT26E5 |
| Applications: | WB, ELISA, ICC/IF |
| Reactivity: | Human |
| Details: | Mouse IgG1 kappa Monoclonal Clone #4F9 |
| Applications: | IHC, WB, ELISA |
| Reactivity: | Human |
| Details: | Rabbit IgG Polyclonal |
| Applications: | IHC, WB |
| Reactivity: | Human |
| Details: | Rabbit IgG Polyclonal |
| Applications: | IHC, ICC/IF |
| Reactivity: | Human |
| Details: | Rabbit IgG Polyclonal |
| Applications: | IHC |
| Reactivity: | Human |
| Details: | Rabbit IgG Polyclonal |
| Applications: | WB |
| Reactivity: | Human |
| Details: | Rabbit IgG Polyclonal |
| Applications: | WB |
| Reactivity: | Human |
| Details: | Mouse IgG1 kappa Monoclonal Clone #AT26E5 |
| Applications: | WB, ELISA, ICC/IF |
| Reactivity: | Human |
| Details: | Rabbit IgG Polyclonal |
| Applications: | IHC, ICC/IF |
Catalog #:
NBP2-59437AFP680
| Reactivity: | Human |
| Details: | Mouse IgG1 kappa Monoclonal Clone #AT26E5 |
| Applications: | WB, ELISA, ICC/IF |
| Reactivity: | Human, Mouse |
| Details: | Rabbit IgG Polyclonal |
| Applications: | IHC, WB, ELISA, IP |
Catalog #:
NBP2-97303AFP594
| Reactivity: | Human |
| Details: | Rabbit IgG Polyclonal |
| Applications: | IHC, ICC/IF |
| Reactivity: | Human |
| Details: | Rabbit IgG Polyclonal |
| Applications: | IHC, ICC/IF |
Catalog #:
NBP2-97303AFP680
| Reactivity: | Human |
| Details: | Rabbit IgG Polyclonal |
| Applications: | IHC, ICC/IF |
Catalog #:
NBP2-97303AFP405
| Reactivity: | Human |
| Details: | Rabbit IgG Polyclonal |
| Applications: | IHC, ICC/IF |
| Reactivity: | Human |
| Details: | Mouse IgG1 kappa Monoclonal Clone #AT26E5 |
| Applications: | WB, ELISA, ICC/IF |
Catalog #:
NBP3-21429AFP488
| Reactivity: | Human |
| Details: | Rabbit IgG Polyclonal |
| Applications: | IHC |
Catalog #:
NBP2-97303AFP647
| Reactivity: | Human |
| Details: | Rabbit IgG Polyclonal |
| Applications: | IHC, ICC/IF |
Catalog #:
NBP2-59437AFP647
| Reactivity: | Human |
| Details: | Mouse IgG1 kappa Monoclonal Clone #AT26E5 |
| Applications: | WB, ELISA, ICC/IF |
Catalog #:
NBP2-59437AFP594
| Reactivity: | Human |
| Details: | Mouse IgG1 kappa Monoclonal Clone #AT26E5 |
| Applications: | WB, ELISA, ICC/IF |
Catalog #:
NBP2-97303AFP488
| Reactivity: | Human |
| Details: | Rabbit IgG Polyclonal |
| Applications: | IHC, ICC/IF |
Catalog #:
NBP3-21429AFP594
| Reactivity: | Human |
| Details: | Rabbit IgG Polyclonal |
| Applications: | IHC |

![Immunohistochemistry-Paraffin: SHMT1 Antibody [NBP1-85437] Immunohistochemistry-Paraffin: SHMT1 Antibody [NBP1-85437]](https://resources.bio-techne.com/images/products/SHMT1-Antibody-Immunohistochemistry-Paraffin-NBP1-85437-img0014.jpg)
![Western Blot: SHMT1 Antibody [NBP2-32173] Western Blot: SHMT1 Antibody [NBP2-32173]](https://resources.bio-techne.com/images/products/SHMT1-Antibody-Western-Blot-NBP2-32173-img0002.jpg)
![Western Blot: SHMT1 Antibody (AT26E5)BSA Free [NBP2-59437] Western Blot: SHMT1 Antibody (AT26E5)BSA Free [NBP2-59437]](https://resources.bio-techne.com/images/products/SHMT1-Antibody-AT26E5-Western-Blot-NBP2-59437-img0001.jpg)
![Western Blot: SHMT1 Antibody (4F9) [H00006470-M01] Western Blot: SHMT1 Antibody (4F9) [H00006470-M01]](https://resources.bio-techne.com/images/products/SHMT1-Antibody-4F9-Western-Blot-H00006470-M01-img0010.jpg)
![Immunohistochemistry-Paraffin: SHMT1 Antibody [NBP3-17022] Immunohistochemistry-Paraffin: SHMT1 Antibody [NBP3-17022]](https://resources.bio-techne.com/images/products/SHMT1-Antibody-Immunohistochemistry-Paraffin-NBP3-17022-img0004.jpg)
![Immunohistochemistry-Paraffin: SHMT1 Antibody [NBP2-97303] Immunohistochemistry-Paraffin: SHMT1 Antibody [NBP2-97303]](https://resources.bio-techne.com/images/products/SHMT1-Antibody-Immunohistochemistry-Paraffin-NBP2-97303-img0003.jpg)
![Immunohistochemistry-Paraffin: SHMT1 Antibody [NBP3-21429] SHMT1 Antibody Immunohistochemistry-Paraffin: SHMT1 Antibody [NBP3-21429]](https://resources.bio-techne.com/images/products/nbp3-21429_rabbit-shmt1-pab-8520231156025.png)
![Western Blot: SHMT1 Antibody [NBP1-53192] Western Blot: SHMT1 Antibody [NBP1-53192]](https://resources.bio-techne.com/images/products/SHMT1-Antibody-Western-Blot-NBP1-53192-img0002.jpg)
![Western Blot: SHMT1 Antibody [NBP2-20353] Western Blot: SHMT1 Antibody [NBP2-20353]](https://resources.bio-techne.com/images/products/SHMT1-Antibody-Western-Blot-NBP2-20353-img0001.jpg)
